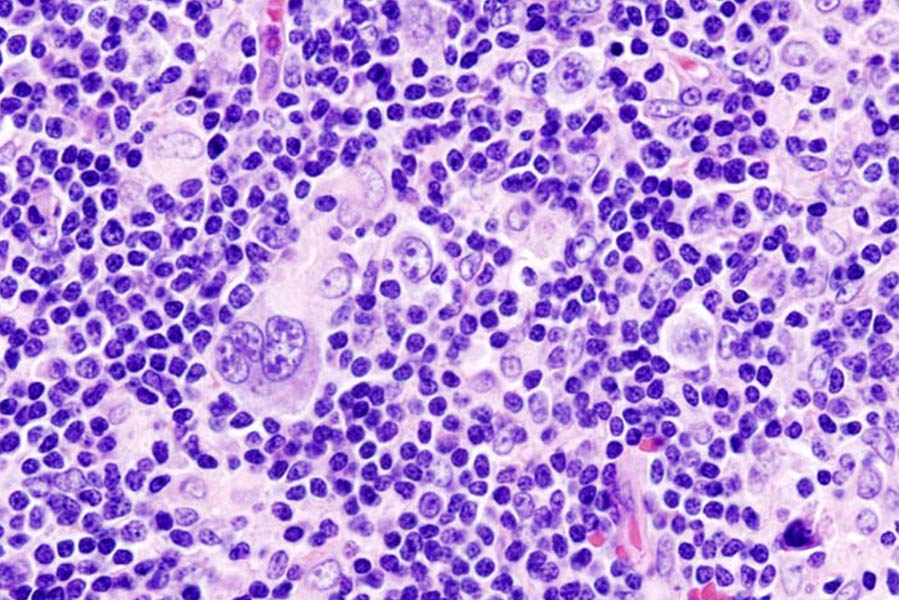
Hodgkin lymphoma biopsy demonstrating rare Hodgkin and Reed-Sternberg cells in a dense immune infiltrate.

Dr. Lisa Giulino Roth, a pediatric oncologist at NewYork-Presbyterian/Weill Cornell Medicine, recently led the first whole-genome sequencing study of Hodgkin lymphoma, the most common cancer in adolescents and young adults. Among the study’s many complex challenges was isolating malignant Reed-Sternberg cells, which represent less than 1% of the tumor. In doing so, the team first isolated 500–3000 Reed- Sternberg cells from stromal cells in samples, and then optimized their sequencing platforms for extremely low input. The investigators also clarified the molecular evolution of the disease. Published in Blood Cancer Discovery, this groundbreaking study could contribute to the development of novel targeted therapies and expand the use of existing treatments, based on the identification of driver mutations.